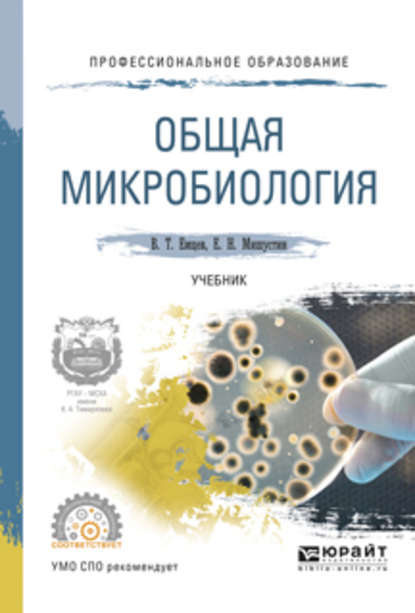
img

Сельскохозяйственная микробиология. Практическое пособие
Автор: Евгений Николаевич Мишустин
Жанры:
Серия: Профессиональная практика
Язык: Русский
Тип: Текст
Опубликовано здесь:
Файл подготовлен:
Пособие посвящено практическому использованию микроорганизмов в различных технологических процессах сельского хозяйства. Большинство материалов основаны на новейших достижениях экологической биотехнологии и поэтому представляют интерес не только для студентов, но и для специалистов сельскохозяйственного производства. Всем, кто хочет более основательно изучить отдельные проблемы общей и сельскохозяйственной микробиологии, будет полезен приведенный в конце книги список монографий, учебников и различных руководств.
Полная версия:
Серия "Профессиональная практика"
Все книги серии